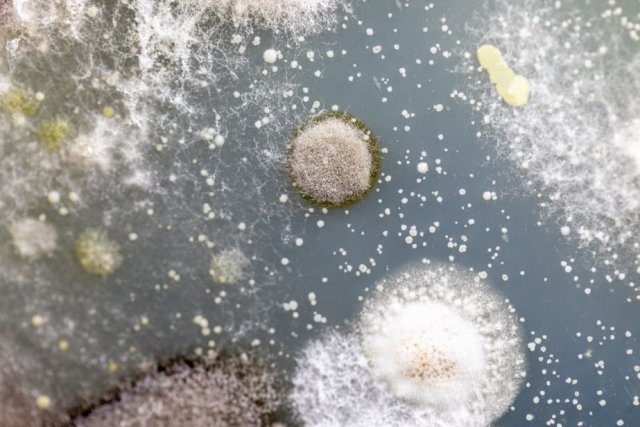
0003438690_002_20220707161201110.jpg?type=w647

곰팡이만 도려내고 먹는다고요? “통째로 버리세요…간암 유발 우려”
게티이미지뱅크곰팡이가 피기 쉬운 덥고 습한 날씨가 이어지면서 곰팡이독소에 노출될 가능성이 커져 주의가 필요하다. 곰팡이독소를 섭취하면 간장, 신장, 신경계 등에 피해를 입을 수 있다. 따라서 식빵 등에 곰팡이가 폈다면 도려내 먹지 말고 통째로 버려야 한다.
식품안전정보원에 따르면 고온다습한 환경에서는 식품에 곰팡이가 생길 수 있는데, 일부 식품에 핀 곰팡이는 아플라톡신, 오크라톡신 등의 곰팡이독소를 생성해 각종 질환을 유발할 우려가 있다.
곰팡이독소는 열에 강해 조리 후에도 완전히 제거되지 않고, 곰팡이가 핀 부분을 잘라내도 보이지 않는 곰팡이 포자나 독소가 식품 전체에 퍼져있을 수 있다. 따라서 곰팡이가 핀 식품은 통째로 버리는 것이 안전하다.
곰팡이독소를 예방하기 위해선 식품을 습하지 않고 온도 변화가 적은 곳에 보관해야 한다. 개봉 후에는 밀봉해 보관하는 게 좋다. 껍질이 있는 식품은 껍질째 보관해야 한다. 상처가 있거나 변색된 부분이 많은 곡류·견과류는 섭취하지 말아야 한다.
게티이미지뱅크식품의약품안전처 박희라 연구관은 7일 YTN라디오 ‘슬기로운 라디오생활’과 인터뷰에서 “곰팡이독소는 곰팡이가 생성하는 2차 대사산물”이라며 “주로 탄수화물이 풍부한 곡류나 두류, 견과류에서 주로 발견되는데, 현재 약 400여 종의 곰팡이독소가 알려져 있다”고 설명했다.
그는 이어 “곰팡이독소는 다양한 식품에서 발견될 수 있다”며 “곡류, 두류, 견과류, 건조과실류, 향신료 같은 원료에서 주로 발견되는데, 이러한 원료를 건조하거나 분쇄하는 등 단순 가공을 거친 식품, 오염된 원료로 만든 땅콩버터나 장류, 포도주스 등의 가공식품에서도 발견된다”고 덧붙였다.
게티이미지뱅크또 박 연구관은 “곰팡이가 핀 부분만 도려내고 먹더라도 곰팡이독소 노출을 피하기 어려우므로 먹지 않는 것이 안전하다”며 “쌀을 씻을 때 씻은 물이 푸른색 혹은 검은색을 띄게 될 경우가 있는데, 이때도 쌀에 곰팡이가 오염되었을 가능성이 있으므로 섭취하지 않는 것이 좋다”고 말했다.
곰팡이독소를 섭취하면 간장, 신장, 신경계 등에 피해를 입을 수 있다. 박 연구관은 “일부 곰팡이독소는 발암물질로도 알려져 있다. 그중에서도 견과류에서 많이 발생하는 아플라톡신B1은 사람에게 간암을 일으킬 수 있는 물질로, 더욱 주의하셔야 한다”며 “곡류 등 우리가 주식으로 섭취하는 식품에서 곰팡이독소가 주로 발견되기 때문에 지속적인 안전 관리가 필요하다”고 강조했다.
.jpg)